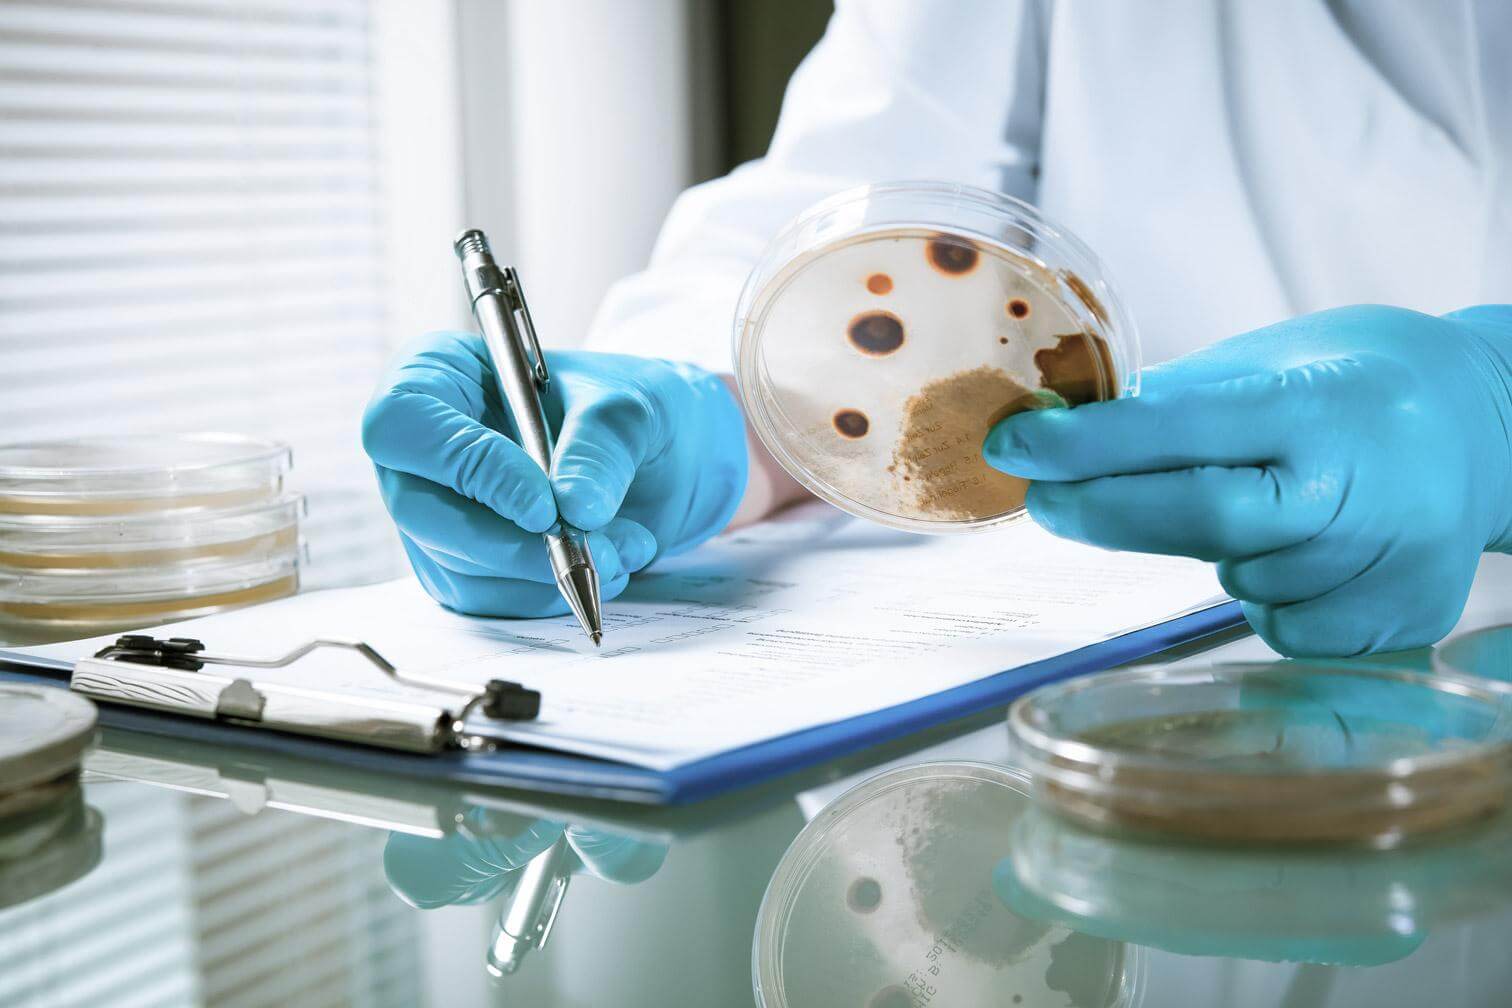
Food and Drug Lab Tech Testing for Contamination Risk

Choose Food Grade Electrical Infrastructure
Food grade support solutions can significantly reduce the risk of contamination for food and drug manufacturers, acting as an insurance policy against the risk and high cost of product recalls. That begs the question: What does “food grade” mean?
There are over 35 statutes regulating food product safety in the U.S. As far as the FDA and United States Department of Agriculture are concerned, however, regulation primarily addresses those areas that are more directly related to actual product manufacturing. Consequently, much of the facility infrastructure needed for the successful operation of the facility could be a contamination risk due to physical construction and limited regulations regarding their use in food and drug production environments.
Given this, food manufacturers should opt for infrastructure platforms that are purposefully designed for use in food and drug production. Creating infrastructure built with food production in mind requires independently seeking out and obtaining food-grade certifications from independent third-party agencies like NSF.
- NSF Certification: NSF is an independent, global product safety certification organization. NSF is the only organization that certifies whether a product is considered “food grade” — not the FDA, USDA, or any other US Government regulatory body. NSF tests and certifies products against rigorous testing standards before granting certification. NSF certification also includes an annual review to ensure ongoing compliance.
- The Hygienic Shield: The Robroy® Hygienic symbol identifies products intended for use in the installation of electrical raceways for sanitary applications.
Food grade solutions receive these hygienic certifications because they address and eliminate the core design flaws in traditional strut systems that make them unsafe for use as electrical infrastructure in food production. Food manufacturers should also opt for infrastructure platforms that are purposefully designed for use together to ensure the best installation. Products marked to indicate purposeful design can facilitate proper selection and installation of the desired platform products.
Rocket Rack® Vastly Improves on Traditional Strut Systems
The contamination risks associated with traditional strut systems are real and could cost your business millions of dollars. Recognizing the significant need in the industry, we designed our patented Rocket Rack® system to solve the problems created by traditional unistrut systems.
Rocket Rack® is certified by NSF showing independent evidence that its design and construction promote food safety.
Rocket Rack® is certified by NSF showing independent evidence that its design and construction promote food safety. It also proudly bears the Hygienic Shield mark as one of the few infrastructure support systems on the market that is designed for manufacturers that need completely hygienic installations.
Rocket Rack® provides all of the benefits found with traditional unistrut systems, and then vastly improves on them. Alongside existing as a food-grade solution versus traditional strut systems, Rocket Rack® also offers:
- No need for time-consuming, messy on-site fabrication such as drilling, cutting, welding
- No need to remove paper labels
- Flexibility and the ability to accommodate last-minute changes due to patented slot design
- Ability to add additional lines in the future due to patented slot design
- Cut-to-length rods with FDA-compliant coating and rod stripping tool to quickly and safely reveal precisely the amount of threads needed
- Designs that allow for mounting via trapeze, wall, or post
- Promotes on-the-job safety
Ready to make a change? The Rocket Rack® platform is also available with three rack types (tented, standard, and flat), multiple mounting methods, hardware, and accessories to facilitate installation, as well as standardized and custom sizes and lengths.
Contact us today to learn more and check out our Rocket Rack® product catalog.